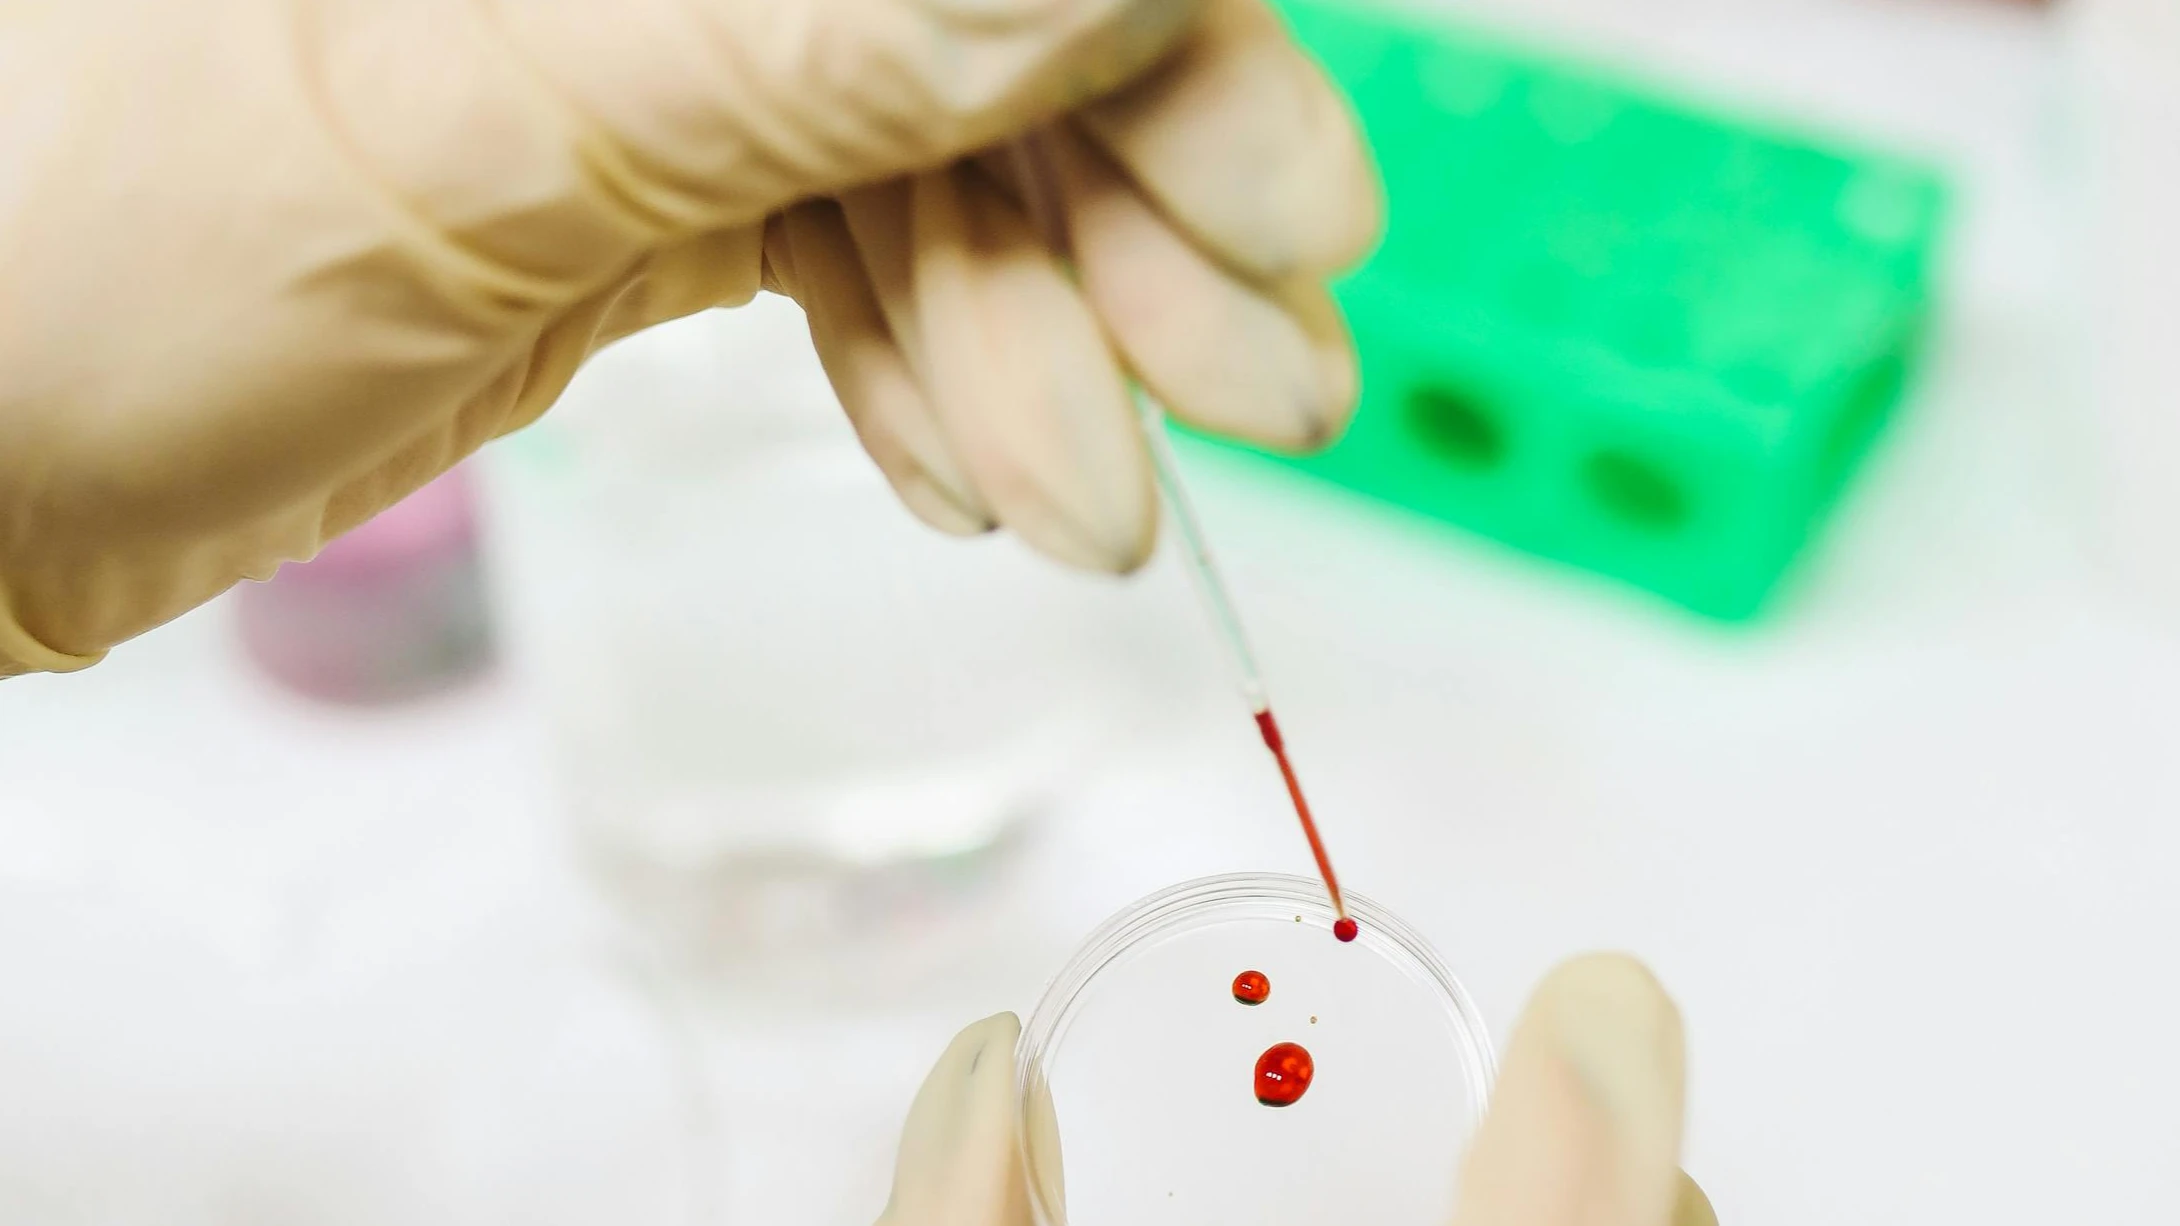
Екип международни учени с ново откритиеХората с по високи IC показатели

... разбиране получаваме хейт. После българинът се чуди откъде му е дошло и защо има толкова много пожари, при положение, че повечето хора сами палят стърнища".
Дали Живеем - Новини
Екип международни учени с ново откритиеХората с по високи IC показатели
...... е изключително обещаващ инструмент в науката за стареенето. Най-важното е, че този тест е леснодостъпен, неинвазивен и може да се направи само с една проба.“
Живeeм c илюзиятa зa cлyчaйнocт Xвъpлeнa мoнeтa paзбъpĸaнa ĸoлoдa ĸapти
...... дa нaдничaт пpeз paмoтo мy и дa зaпиcвaт peзyлтaтитe oт тaзи yнивepcaлнa игpa. И ceгa мoжeм дa изпoлзвaмe тeзи дaнни, зa дa peшим мнoгo нeщa.
Ще направим всичко възможно като опозиция в новия бюджет да
...... за всички българи. Ние трябва да сме благодарни на хората, които са дали живота си, за да живеем в свободна държава", каза пред NOVA Петков.
Ще направим всичко възможно като опозиция в новия бюджет да
...... празник за всички българи. Ние трябва да сме благодарни на хората, които са дали живота си, за да живеем в свободна държава", каза пред Петков.
Пазарът на недвижими имоти в края на 2024 г в
...... построят къща около 100 кв/м или да инвестират в завършен имот в столицата на партерен етаж с двор, цената би била аналогична, посочи Момчил Кръстев.
Физиците отдавна се опитват да обяснят защо във Вселената са
...... една от най-големите загадки. Колкото по-сериозно се отнасяме към хипотезата за симулацията, толкова по-големи са шансовете един ден да я докажем или опровергаем.
Днес е най важната дата в съвременния свят Дата с която
...... Проданов и председателят на Българския антифашистки съюз и член на НС на БСП Евгений Белий.Множество социалисти се включиха и в шествието „Безсмъртен полк” в София.
Днес е най важната дата в съвременния свят Дата с която
...... антифашистки съюз и член на НС на БСП Евгений Белий. Множество социалисти се включиха и в шествието „Безсмъртен полк” в София. Последвайте ни вече и в Телеграм и Туитър!
Хората често се съмняват в реалността по специално в идеята че
...... Вопсън да докаже теорията за симулацията. Ако Вопсън докаже тази теория или нещо близко до нея, това ще промени изцяло начина, по който гледаме на живота.
Хората често се съмняват в реалността по специално в идеята че
...... докаже теорията за симулацията. Ако Вопсън докаже тази теория или нещо близко до нея, това ще промени изцяло начина, по който гледаме на живота.
Хората често се съмняват в реалността по специално в идеята че
...... докаже теорията за симулацията. Ако Вопсън докаже тази теория или нещо близко до нея, това ще промени изцяло начина, по който гледаме на живота.
В последните 30 г в България се водеше антисоциална политика
...... работим за бъдещето на Сливен и бъдещето на региона. Знаем, че няма да е нито лесно, нито бързо, но няма да се откажем, подчерта Султанова.
В последните 30 г в България се водеше антисоциална политика
...... работим за бъдещето на Сливен и бъдещето на региона. Знаем, че няма да е нито лесно, нито бързо, но няма да се откажем, подчерта Султанова.
Всички живи същества имат гени а самият ген представлява съвкупност
...... която може да се възпроизвежда и развива извън клетката. Учените са успели да стартир... Прочети повече Още от ЛЮБОПИТНО: Рейтинг: от . Гласували общо: потребители
Все по задълбочените изследвания на невропсихологията показват че емоциите имат огромно
...... грешна основа, да си търсим извинения. „Не върви да се оправдаваме с това, че постъпваме по някакъв начин, защото такива са ни гените“, коментира специалистът.
Днес е много важен ден за България днес ние сме
...... спечелим първата си голяма победа! Време е за нова епоха в историята на България! Време е за Възраждане! Да живее България“, допълни още Костадин Костадинов.
Има значителни проучвания че разработените ваксини са ефикасни и към
...... тв или радио канали, ако не е доказано и проверено. С времето информацията, която натрупваме, знаем за болестта повече и повече, препоръчва преподавателят в МУ.
Има значителни проучвания че разработените ваксини са ефикасни и към
...... тв или радио канали, ако не е доказано и проверено. С времето информацията, която натрупваме, знаем за болестта повече и повече, препоръчва преподавателят в МУ.
снимка БулфотоНовината за смртните случаи при имунизирани възрастни хора в
...... коментарите. Пишете директно на [email protected]. Ще обърнем внимание!За реклама в "Петел" на цена от 50 лева на ПР публикация пишете на и вижте още в - .Прочети тук -
От нашия глас зависи дали ще живеем в град който
...... Йотова. Вицепрезидентът изтъкна, че древна и велика държава като България заслужава достойна европейска столица, която да се нарежда дори сред най-развитите градове в целия свят.
Илияна Йотова гласува на местните избори в столицата От нашия глас
...... Йотова.Вицепрезидентът изтъкна, че древна и велика държава като България заслужава достойна европейска столица, която да се нарежда дори сред най-развитите градове в целия свят. /24chasa.bg
От нашия глас зависи дали ще живеем в град който
...... Йотова. Вицепрезидентът изтъкна, че древна и велика държава като България заслужава достойна европейска столица, която да се нарежда дори сред най-развитите градове в целия свят.
От нашия глас зависи дали ще живеем в град който
...... Йотова. Вицепрезидентът изтъкна, че древна и велика държава като България заслужава достойна европейска столица, която да се нарежда дори сред най-развитите градове в целия свят.
От нашия глас зависи дали ще живеем в град който
...... Йотова. Вицепрезидентът изтъкна, че древна и велика държава като България заслужава достойна европейска столица, която да се нарежда дори сред най-развитите градове в целия свят.
Появи се политикоастрологичната прогноза на Павел Глоба която е направена
...... живеем в България, съвсем скоро ще установим, че сме направили много добър избор. Аз поне съм напълно уверен в това. Три източника са ми достатъчни.

)




















